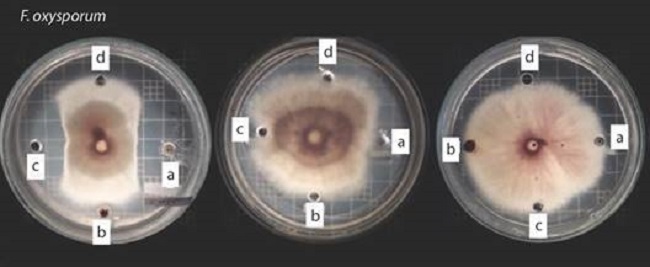
Agar- well diffusion method using F. oxysporum as a test microorganism. Left plate: UFAB25 biosurfactant extracts, center plate: UFAB29. right plate: UFAB19. Well A. contains 50 µL of Bs1, B. 50 µL FBs1, C. 50 µL of Bs2, and D. 50 µl of methanol (control).

Artículo
Antifungal potential of biosurfactants produced by strains of Bacillus spp. (Bacillales: Bacillaceae) selected by molecular screening
Potencial antifúngico de biosulfactantes producidos por cepas de Bacillus spp. (Bacillales: Bacillaceae) seleccionadas por tamizaje molecular
Antifungal potential of biosurfactants produced by strains of Bacillus spp. (Bacillales: Bacillaceae) selected by molecular screening
Revista de Biología Tropical, vol. 70, no. 1, pp. 636-646, 2022
Universidad de Costa Rica
Received: 13 January 2022
Revised document received: 22 June 2022
Accepted: 07 September 2022
Abstract
Introduction: Bacillus species are used as biological controllers for phytopathogenic fungi, and the mechanisms to produce controllers include biosynthesis of lipopeptide biosurfactants with antifungal activity.
Objective: To evaluate the antifungal potential of the biosurfactants produced by Bacillus strains, selected by molecular screening, on Fusarium oxysporum.
Methods: We selected four molecular markers, related to the biosynthesis of surfactin, fengicin, and lichenysin (srfA, spf, fenB, LichAA) in nine Bacillus strains. We used two mineral media with several culture conditions, for biosurfactant production, and a well diffusion test for antifungal potential.
Results: Only the biosurfactant produced by UFAB25 inhibits the mycelial growth of F. oxysporum (44 % ± 13): this biosurfactant was positive for srfA, spf, and fenB genes involved in the synthesis of surfactin and fengicine. Antifungal activity depends on culture conditions and the strain.
Conclusions: Genetic markers are useful to detect strains with antifungal potential, facilitating the selection of bio-controllers. The biosurfactant profile is influenced by the strain and by culture conditions.
Key words: microbial surfactant+ native strains+ Bacillus subtilis+ antifungal activity+ molecular marker.
Resumen
Introducción: Especies de Bacillus han sido empleadas como controladores biológicos contra hongos fitopatógenos. Entre los mecanismos utilizados se destaca la biosíntesis de biosurfactantes lipopeptídicos con actividad antifúngica.
Objetivo: Evaluar el potencial antifúngico de los biosurfactantes producidos por cepas Bacillus nativas, previamente seleccionadas mediante tamizaje molecular, sobre Fusarium oxysporum.
Métodos: Se utilizaron cuatro marcadores moleculares, relacionados con la biosíntesis de surfactina, fengicina y liquenisina (srfA, spf, fenB, LichAA) sobre nueve cepas de Bacillus. Se utilizaron dos medios minerales con diferentes condiciones de cultivo para la producción del biosurfactante. Se evaluó el potencial antifúngico de los biosurfactantes mediante la prueba de difusión en pozos.
Resultados: Se determinó que solo el biosurfactante producido por UFAB25 actúa como inhibidor del crecimiento micelial de Fusarium oxysporum (43.6 % ± 13), esta cepa es positiva para los genes srfA, spf y fenB, involucrados en la síntesis de surfactina y fengicina. La actividad antifúngica depende de las condiciones de cultivo y la cepa.
Conclusiones: Los marcadores genéticos ayudan a detectar cepas con potencial antifúngico, facilitando la selección de biocontroladores. El perfil del biosurfactante está influenciado no solo por la cepa, sino también por las condiciones del cultivo.
Palabras claves: surfactantes microbianos, cepas nativas, Bacillus subtilis, actividad antifúngica, marcador molecular.
Introduction
The excessive use of pesticides has several negative impacts on human health and in the environment such as the decrease in fertility of agricultural lands, contamination of water sources, and affectation of fauna and flora (Mahmood et al., 2016; Rajmohan et al., 2020; Wilson & Tisdell, 2001). One of the main drawbacks has been the emergence of resistance and the involuntary destruction of natural predators of pest organisms (Litsinger, 1989; Wilson & Tisdell, 2001). Due to the problems associated with the use of pesticides, there is a need to seek new sustainable and environmentally friendly technologies in agriculture. Among such alternatives, the study and development of biopesticides and bio-controllers stand out (Borriss, 2011).
Bacillus genus is a group of gram-positive bacteria forming endospore, with the ability to produce a large number of molecules with inhibitory potential against phytopathogens (Ben-Dov et al., 1997; Ogena & Jacques, 2008). These bacteria are able to colonize the rhizosphere with beneficial effects on plants. They can tolerate environments with high alkalinity, acidity, salinity, and temperature (Horikoshi, 2007). Between 4 % and 5 % of Bacillus subtilis genome is involved in the synthesis of antibiotics, while 9 % of Bacillus amyloliquefaciens genome is dedicated to the production of secondary metabolites that suppress harmful microbes and nematodes (Chowdhury et al., 2015; Ogena & Jacques, 2008)
Among the metabolites produced by the genus Bacillus, with biocontrol properties, are the lipopeptides of the surfactin, iturin, and fengicin families (Mnif et al., 2015; Ogena & Jacques, 2008). They are amphipathic molecules with surfactant properties. The latter possessed a strong antifungal activity and surfactins exhibit antibacterial properties. The coproduction of different families of lipopeptides generates a synergistic effect on their biological activities (Ongena et al., 2005)
A study demonstrated that surfactins and fengicins may be involved in the development of induced systemic resistance (ISR) acting as elicitors. The results suggest that they provided a significant protective effect in bean plants, similar to that induced by cells of the B. subtilis strain S449 (Ogena & Jacques, 2008; Ongena et al., 2007).
The aim of this study is to use molecular screening to identify native strains that are able to produce biosurfactant with antifungal potential. These strains have been collected from different environmental sources in Ecuador and are meant to be researched at laboratory level.
Materials and methods
Microorganisms: The bacterial and the Fusarium oxysporum strains were provided by the Environmental Microbiology Laboratory of the Universidad de las Fuerzas Armadas ESPE in Ecuador. The strains were isolated from different environmental sources such as contaminated soils and hydrothermal springs from the tropical Andes of Ecuador, under the permit # MAE-DNB-CM-2017-0071 as granted by the Environment Ministry of Ecuador.
All the native strains were identified using the 16S rRNA molecular marker in previous studies (Table 1). The microorganisms were reactivated following the protocol of Freire & Sato (1999). Streaking technique was performed in Nutrient Agar to confirm colony morphology and Gram staining.

Hemolytic activity: It is a qualitative, rapid screening method used to identify biosurfactant-producing microorganisms (Thavasi, et al., 2007; Youssef et al., 2004). The test was performed on blood agar plates, where each strain was streaked onto blood agar plates and incubated at 37 °C for 42 h. Subsequently, beta hemolysis (clear area) was identified around the colonies as a positive result for the production of biosurfactants, according to the protocol proposed by Youssef et al. (2004) with some modifications. Hereby, the notation “-” was used for no hemolysis, “+”; for incomplete hemolysis (greenish area), “++”; for complete hemolysis with a lysis diameter less than 1 cm, and “+++”; for complete hemolysis with a lysis diameter greater than or equal to 1 cm.
Molecular screening: Bacterial genomic DNA was extracted from a 24 h culture of each strain using the modified protocol of Jarrin (2010). The quality of DNA was determined by the A260/A280 absorbance ratio, considering values of 1.8-2 as pure DNA (Sambrook & Russell, 2001). Finally, DNA concentrations were adjusted to 40 ng/µL.
PCR was performed for each gene (srf, srfAA, fenB, and LinchAA). Primers and annealing temperatures are listed in Table 2. PCRs were conducted in a total volume of 25 µL with 6.5 µL of nuclease-free water, with 12.5 µL of GoTaq® Green Master Mix 2X Promega, 0.6 µM of each primer, and 3 µL of genomic DNA. PCR programs were at 95 °C for 2 min, with 35 cycles of 95 °C for 30 s, while annealing temperature for 30 s and 72 °C for 30 s. A final extension step was realized at 72 °C for 7 min, followed by storage temperature at 4 °C. PCR products were visualized on an agarose gel.

PCR products were sequenced by Macrogen Korea using Sanger technology (Chan, 2005). Forward and reverse sequences were cleaned using Geneius and Mega7 programs until an acceptable quality was obtained (HQ > 85 %). Resulting counting sequences were compared with the tool BLAST of database NCBI (National Center of Biotechnology Information) (Sherry et al., 2001).
Biosurfactant production and extraction: Based on the results obtained in the molecular screening and hemolytic activity, three strains (UFAB 19, UFAB 29, UFAB25) were selected out of nine. Subsequently, two protocols were used for biosurfactant production.
Protocol one: The inoculum was prepared according to the protocol used by Ghribi & Ellouze-Chaabouni (2011). Each strain was inoculated into 3 mL of LB medium and incubated at 37 °C overnight. A 0.2 mL aliquot was inoculated into 50 mL of LB medium in a 250 mL Erlenmeyer flask and incubated with shaking at 37 °C until an absorbance of 3 was reached at a wavelength of 600 nm. An aliquot of the culture was inoculated in a mineral medium until an initial optical density of 0.15 corresponding to 0.8 x 107 CFU/mL was reached.
The optimized medium, proposed by Mnif et al. (2013), was used. It contains 15 g/L glucose, 7.5 g/L urea, 1 g/L K2HPO4, 1 g/L ammonium sulfate, 0.5 g/L NaCl, 0.2 g/L MgSO4, 0.5 g/L KH2PO4, and 0.001 g/L of each of the following MnSO4, FeSO4, ZnSO4, 1 and CaCl2. The culture was conducted in 150 mL of medium in 500 mL flasks, at 30 °C, and 150 rpm for three days.
Protocol two: A second medium, described by El-Sheshtawy et al. (2015) was tested. A 5 mL aliquot of a 24 h bacterial culture on nutrient broth was used as inoculum. The medium presented the following composition: 2 % glucose, 3 % yeast extract, 2.5 g/L NaNO3, 0.1 g/L KCl, 3.0 g/L KH2PO4, 7.0 g/L K2HPO4, 0.01 g/L CaCl2, 0.5 g/L MgSO4 x 7H2O and 5 mL of a solution of microelements; 0.116 g/L FeSO4 * 7H2O, 0.232 g/L H3BO3, 0.41 g/L CoCl2 6H2O, 0.008 g/L CuSO4 * 5H2O, 0.008 g/L MnSO4 x H2O, 0.022 g/L [NH4]6 Mo7O24 and 0.174 g/L ZnSO4. The culture was performed in 500 mL, using completely filled screw cap flasks, incubated at 30 ºC and 150 rpm for three days.
Surfactant production verification: The biosurfactant production was verified using the crude dispersion test according to the methodology described by Youssef et al (2004) with modifications. 20 µL of crude oil was added to 50 mL of distilled water in a Petri dish. Then, one drop (~ 10 µL) of cell-free culture was added. The formation of a clear zone on the surface of the crude oil was determined visually as positive for the production of microbial surfactants. The formation of clear areas was not observed with the control test when using distilled water.
Biosurfactant extraction: The biosurfactant was extracted according to Li et al. (2010) with modifications. The broth culture was centrifuged at 6 000 rpm for 20 min in order to separate lipopeptides of interest from biomass. Hereafter, supernatant was acidified to a pH of 2.0 by adding concentrated HCl and stored at a temperature of 4 °C for 12 h. The precipitated biosurfactant was collected by centrifugation and recovered in methanol. Finally, the solvent was removed by evaporation.
Antifungal potential: Agar-well diffusion method was used to evaluate the antifungal activity of the biosurfactant extracts. In a Plate of Potato Dextrose Agar (PDA) four wells were generated 3 cm away from the center of the plate, where a mycelial plug with a diameter of 0.5 cm of F. oxysporum was inoculated. 50 µL of methanol was placed in the control well, then 50 µL of the biosurfactant solutions were loaded in the rest of the wells.
The solutions tested were the following, “Bs1”: a 50 % v/v methanol solution with the biosurfactant produced with protocol one, “FBs1”: an unsaturated methanol fraction obtained from the supernatant of the “BS1” solution after the precipitation of biosurfactant in excess. Finally, “Bs2”: a 50 % v/v methanol solution with the surfactant produced with protocol two.
The inhibition of the phytopathogen was quantified when mycelial growth had reached the control well. The following formula was used to determine mycelial growth inhibition percentage.
I=[(C - T)/C]*100
Where “C” is the radial distance of mycelial growth towards the control well, “T” is the radial distance of mycelial growth towards the well with the extract, and “I” is the inhibition percentage (Ramarathnam et al., 2007). The experiments were conducted by triplicate.
A normal distribution of the data was considered. A two-way ANOVA test and means comparison Bonferroni test were performed (St & Wold, 1989). The factors are strains (UFAB25, UFAB29, UFAB19) and biosurfactant solution (Bs1, FBs1, Bs2). Origin Pro (OriginLab, 2018) was the program used.
Results
Hemolytic activity: 55.5 % of the strains (UFAB25, UFAB28, UFAB29.1, UFAB29, and UFAB31.5) generated complete hemolysis. Results are listed in Table 3.

Molecular screening: A molecular screening was used as a selection criterion for the strains used in the production of biosurfactants. 22.2 % of the nine strains tested presented the sfp and srf-AA genes, involved in the production of surfactin. Only UFAB25 was positive for fenB gene. While 33.3 % of the reactivated strains (UFAB25, UFAB29, UFAB19) were positive for the Lich-AA gene. The results of the comparison, made in BLAST with the sequences obtained, are shown in Table 4. The other four strains (UFAB26, UFAB28, UFAB29.1, UFAB31) were negative for sfp, srf-AA, Lich-AA and fenB genes.

Biosurfactant production: Strain Selection: Based on the results obtained in the molecular screening and hemolytic activity, three strains were selected: UFAB19 does not show any hemolytic activity, but it has genes associated with linchenysin biosynthesis (this strain was used as a negative control). UFAB25 and UFB29, yielded hemolytic activity and displayed genes associated to fengicin and surfactin. No other molecular screen-negative strains were selected to optimize resources and work.
The production of the biosurfactant in mineral medium was verified by the oil dispersion test. The largest crude oil dispersion diameter of crude oil (26.3 mm) corresponded to strain UFAB29 strain, while the dispersion area with the smallest diameter (5.7 mm) was with strain UFAB19, both in the mineral medium proposed by Mnif et al. (2013). All the supernatants tested generated crude oil displacement, confirming the production of biosurfactants. Table 5 lists the results of the oil dispersion test.

SD: standard deviation.
Antifungal potential: The biosurfactant produced by the UFAB25 strain (B. subtilis) in the first mineral medium yielded the highest percentage inhibition of mycelial growth of F. oxysporum. The 50 % v/v methanol solution (Bs1) had a mycelial percentage inhibition of 43.6 ± 13.16. The methanol fraction obtained from the 50 % v/v solution (FBs1) had an average percent inhibition of 40.9 ± 12.38. While a 50 % v/v methanol solution of biosurfactant produced with second mineral medium (Bs2) reaches an inhibition percentage of 19.7 ± 10.84. The solution biosurfactant produced with UFAB29 (B. subtilis) Bs1, Bs2 and, FBs1 showed percent inhibition of 7.46 ± 2.19, 0.91 ± 1.92 and 1.49±1.97, respectively. While Bs1 and Bs2 produced with UFAB19 (B. licheniformis) reach 0.46 ± 0.80 and 0.10 ± 1.17, respectively (Fig. 1). The yield of UFAB19 biosurfactant in the mineral medium being low, the quantity of extract was insufficient to conduct the methanolic solutions at 50 % v/v, consequently, the solutions were produced at a lower concentration.
Fig. 1
Agar- well diffusion method using F. oxysporum as a test microorganism. Left plate: UFAB25 biosurfactant extracts, center plate: UFAB29. right plate: UFAB19. Well A. contains 50 µL of Bs1, B. 50 µL FBs1, C. 50 µL of Bs2, and D. 50 µl of methanol (control).
The ANOVA test established the interaction between the factors. Hereby, “Biosurfactant solutions” and “Bacterial strains” are statistically significant with a P-value= 0,046. Bonferroni test revealed significant differences between the means obtained with Bs1 and Bs2 for all the strains (P-value= 0.021). The test demonstrated significant differences between the means of UFAB25 with the means of UBA29 and UFAB19 (Fig. 2).

Fig. 2
Bar graph of mycelial growth inhibition results obtained with different biosurfactants solutions. The graph shows the differences between the inhibition actions of the biosurfactans solutions obtained with the tree strains. There is a significance difference (P-value: 0.024) between the results obtained with Bs1 and Bs2 produced with UFAB25.
Discussion
The nine native strains used in the study were isolated in previous studies from different environments, such as oil-contaminated soils and hydrothermal springs with high mineral concentrations. Bodour et al. (2003) mention that a small fraction of the microbial community is able to produce biosurfactants unless there is selective pressure. The production of biosurfactants is an important tool for the survival of producing microorganisms, as it increases the bioavailability of hydrocarbons used as a carbon source (Zang et al., 2021) and it acts as a chelating agent, forming insoluble precipitates of toxic heavy metals (Saranya et al., 2015). That is why soils contaminated with organic substances or metals present a higher percentage of surfactant-producing microorganisms, due to selection pressure. Native strains isolated from soils are valued as biopesticides producers or as biocontrollers based on the long-lasting effect of the biosurfactants as well as the high environmental adaptability of microorganisms in the soil.
Hemolytic activity has been widely used as a qualitative and inexpensive method of biosurfactant production (Mulligan et al., 1984). In the current study strains of B. subtilis, B. cerus, B. toyanensis and B. megaterium were positive for hemolytic activity. Hemolysis generated by B. subtilis has been widely reported since Bernheimer & Avigad (1970) verified the lysis of red blood cells due to the presence of surfactin. B. megaterium is generally reported as non-hemolytic (Hsieh et al. 2004). However, Thavasi et al. (2008) reported a strain of B. megaterium that produces glycolipic biosurfactants, with hemolytic activity. Some strains of B. cereus produce lipopeptides, such as mycocerein (Soberón-Chávez, 2011) and fengicin (Ogena & Jacques, 2008). Nonetheless, the hemolytic capacity may not only be due to the production of biosurfactants but also to the presence of BL hemolysin, a widely reported exotoxin in B. cereus (Beecher et al., 1995). Youssef et al. (2004) mention that the hemolytic test has excluded good producers of biosurfactants, therefore, the rest of the strains cannot be definitively ruled out as biosurfactant producers.
Based on the identification of the genes encoding for antimicrobial lipopeptides, it is possible to study the relationship between their products and biological activity. The isolation and identification of novel antimicrobial-producing Bacillus strains is a promising area of research (Farzand et al., 2019). However, conventional screening methods, in large groups of microorganisms isolated from natural sources, based on their direct antifungal activity are laborious and time-consuming. That is why the use of molecular markers is crucial for the detection of genes in the selection of potential biological controllers (Athukorala et al., 2009; Farzard et al. 2019).
During the molecular screening, all the strains of B. licheniformis presented the Lich-AA gene, involved in the synthesis of lichenysin. Madslien et al. (2013) determined that the vast majority of B. licheniformes strains possess this gene, indicating that a large proportion are capable of producing it. Lichenysin can be used as a surfactant agent in metal extraction, bioremediation processes, textile, paper, and food industries, and as a biofilms controller of pathogenic organisms (Coronel-León et al., 2015a; Coronel-Leon et al., 2015b).
UFAB25 (B. subtilis) was positive for sfp and srfAA genes associated with surfactin production, as well as for the fenB gene involved in fengicin biosynthesis. The discovery of strains capable of producing fengicin and surfactin has been widely documented in members of the species B. subtilis (Ongena et al. 2007; Płaza et al., 2015), even the co-production of surfactin, fengicin, and iturin A, has been reported, although it is very unusual (Kim et al., 2004). The biosurfactant extract produced by UFAB25 inhibited the mycelial growth of F. oxysporum in a percentage of 43.6 ± 13. The potential of B. subtilis biosurfactants to combat several species of the genus Fusarium has been previously reported (Mnif et al., 2015; Ramarathnam et al., 2007). Mnif et al. (2015) indicate that the inhibition of the phytopathogen is due to the lysis of the excess mycelium, polynucleation and destruction of the spores by lipopeptides. Among the metabolites produced by B. subtilis with antifungal activity are lipopeptides of the fengicin and iturin families, while surfactins are attributed antibacterial potential (Ongena & Jacques, 2008). These compounds interact with the cell membranes of phytopathogenic microorganisms generating pores and an osmotic imbalance resulting in cell death (Liu et al., 2014). The mechanism of action of iturin is based on osmotic disturbance due to the formation of conductive pores of fungitoxic K+ ions. Surfactin causes rupture and solubilization of membranes. Fengicin alters the lipid bilayer of the cell membrane structure and affects its permeability (Farzand et al., 2019; Ongena, & Jacques, 2008). The co-production of lipopeptides is able to generate synergistic effects on their biological activities (Perez et al., 2017).
The UFAB29 strain reported as B. subtilis only presented the genetic markers associated with surfactin and showed no relevant inhibition against the phytopathogenic fungus. According to Peypoux et al. (1999) surfactin by itself is not antifungal, so the null action presented could be understood. Perez et al. (2017) reported the strain Bacillus sp. C3, positive for the sfp gene, had practically no action against F. oxysporum. Similarly, Farzand et al. (2019) determined that the B. subtilis OKB105 strain, positive for surfactin, was ineffective in inhibiting the mycelial growth of filamentous fungi. However, the biosurfactant produced by UFAB29 with the first protocol has a crude oil dispersion diameter of 26.3 mm, the diameter of the dispersal zone correlates with the ability of samples to reduce surface tension (Morikawa et al., 2000). Therefore, it could present other potential uses such as the environmental remediation of hydrocarbons.
The only strain that exhibited strong antifungal activity was USFA25 and it was the only strain tested that had genes for fengicin synthesis (fenB). While USFA29, which had srf-AA and sfp genes, had much weaker antifungal activity. These data support that fengicin is the main antifungal agent.
Youssef et al. (2004) mention that oil dispersion test is a reliable method to detect the production of surfactants. This technique is a fast and inexpensive way to directly measure the surface activity of the biosurfactants present in the cell-free medium (Morikawa et al., 2000). Different measures were obtained for the same strain in different production mediums. It is established that the profile (concentration and/or type) of biosurfactants synthesized by the same strain varies according to the medium used, considering that the diameter of the clear area on the surface of the crude oil is related to the concentration and type of biosurfactant in the solution (Youssef et al., 2004)
Differences were observed in the antifungal activity of the lipopeptides synthesized by the UFAB25 strain in different culture media, as well as the results obtained from the crude dispersion test, the influence of the culture conditions is suggested in the biosurfactant profile. Coronel-León et al. (2015a) mention that the nature of the carbon source, the concentration of salts in the medium, and the operating conditions, such as temperature, agitation, and dissolved oxygen are involved in the nature and quantity of biosurtants synthesized.
The native strains isolated from contaminated soils, for instance strain UFAB25, positive for the genes involved in the production of surfactin and fengycin, produced biosurfactants that inhibited the mycelial growth of F. oxysporum. UFAB25 was positive for hemolytic activity and for crude oil dispersion test. The detection of more than one molecular marker involved in the biosynthesis of different lipopeptides with rapid, simple and economic tests as crude oil dispersion and hemolytic activity help to preselect potential bio-controllers. The antifungal activities of the lipopeptides synthesized by the UFAB25 strain in the two culture mediums were different, due to the influence of the culture conditions on the profile of the biosurfactant produced.
Ethical statement: the authors declare that they all agree with this publication and made significant contributions; that there is no conflict of interest of any kind; and that we followed all pertinent ethical and legal procedures and requirements. All financial sources are fully and clearly stated in the acknowledgements section. A signed document has been filed in the journal archives.
Acknowledgments
This study was developed with research funds from CEDIA (Corporación Ecuatoriana para el Desarrollo de la Investigación y la Academia) by project CEPRA XIII-2019-07 “Formulación de biosanitizantes a partir de tensioactivos microbianos para su aplicación en la industria de alimentos” and Universidad de las Fuerzas Armadas - ESPE. We thank the support of the Center of Nanoscience and Nanotechnology (CENCINAT). We are very grateful to Rachid Seqqat, Theofilos Toulkeridis, Carolina Molina and Fernanda Toscano for the significant improvement in the English of the manuscript.
References
Athukorala, S. N., Fernando, W. G., & Rashid, K. Y. (2009). Identification of antifungal antibiotics of Bacillus species isolated from different microhabitats using polymerase chain reaction and MALDI-TOF mass spectrometry. Canadian Journal of Microbiology, 55(9), 1021-1032.
Beecher, D. J., Schoeni, J. L., & Wong, A. C. (1995). Enterotoxic activity of hemolysin BL from Bacillus cereus. Infection and Immunity, 63(11), 4423-4428.
Ben-Dov, E., Zaritsky, A., Dahan, E., Barak, Z., Sinai, R., Manasherob, R., Khamraev, A., Troitskaya, E., Dubitsky, A., Berezina, N., & Margalith, Y. (1997). Extended screening by PCR for seven cry-group genes from field-collected strains of Bacillus thuringiensis. Applied and Environmental Microbiology, 63(12), 4883-4890.
Bernheimer, A. W., Avigad, L. S. (1970) Nature and properties of a cytolytic agent produced by Bacillus subtilis. Journal of General Microbiology, 61, 361-369.
Bodour, A. A., Drees, K. P., & Maier, R. M. (2003). Distribution of biosurfactant-producing bacteria in undisturbed and contaminated arid southwestern soils. Applied and Environmental Microbiology, 69(6), 3280-3287.
Borriss, R. (2011). Use of plant-associated Bacillus strains as biofertilizers and biocontrol agents in agriculture. In D. K. Maheshwari (Ed.), Bacteria in Agrobiology: Plant Growth Responses (pp. 41-76). Springer-Verlag.
Chan, E. Y. (2005). Advances in sequencing technology. Mutation Research, 573(1-2), 13-40.
Chowdhury, S. P., Hartmann, A., Gao, X., & Borriss, R. (2015). Biocontrol mechanism by root-associated Bacillus amyloliquefaciens FZB42 - a review. Frontiers in Microbiology, 6, 780.
Chung, S., Kong, H., Buyer, J. S., Lakshman, D. K., Lydon, J., Kim, S., & Roberts, D. P. (2008). Isolation and partial characterization of Bacillus subtilis ME488 for suppression of soilborne pathogens of cucumber and pepper. Applied Microbiology and Biotechnology, 80(1), 115-123.
Coronel-León, J., Grau, G. D., Grau-Campistany, A., Farfan, M., Rabanal, F., Manresa, A., & Marqués, A. M. (2015a). Biosurfactant production by AL 1.1, a Bacillus licheniformis strain isolated from Antarctica: production, chemical characterization and properties. Annals of Microbiology, 65(4), 2065-2078.
Coronel-León, J., Marqués, A., Bastida, J., & Manresa, A. (2015b). Optimizing the production of the biosurfactant lichenysin and its application in biofilm control. Journal of Applied Microbiology, 120(1), 99-111.
El-Sheshtawy, H., Aiad, I., Osman, M., Abo-Elnasr, A., & Kobisy, A. (2015). Production of biosurfactant from Bacillus licheniformis for microbial enhanced oil recovery and inhibition the growth of sulfate reducing bacteria. Egyptian Journal of Petroleum, 24(2), 155-162.
Farzand, A., Moosa, A., Zubair, M., Khan, A. R., Hanif, A., Tahir, H. A., & Gao, X. (2019). Marker assisted detection and LC-MS analysis of antimicrobial compounds in different Bacillus strains and their antifungal effect on Sclerotinia sclerotiorum. Biological Control, 133, 91-102.
Freire, J., & Sato, M. (1999). Conservación de cultivos de rizobios. Revista Latinoamericana de Microbiología, 41, 35-41.
Ghribi, D., & Ellouze-Chaabouni, S. (2011). Enhancement of Bacillus subtilis lipopeptide biosurfactants production through optimization of medium composition and adequate control of aeration. Biotechnology Research International, 2011, 1-6.
Horikoshi, K. (2007). Past, present and future of extremophiles. Extremophiles, 12(1), 1-2.
Hsieh, F., Li, M., Lin, T., & Kao, S. (2004). Rapid detection and Characterization of Surfactin-Producing Bacillus subtilis and Closely Related Species Based on PCR. Current Microbiology, 49(3), 186-191.
Jarrín, F. (2010). Protocolo de extracción de ADN de bacterias y hongos CTAB-Modificación del Centro Internacional de la PAPA. In A. Carrera, C. Yánez, & E. Morillo (Eds.), Uso y conservación de la biodiversidad de cepas de Azospirillum spp. para la producción y validación de un biofertilizante para el cultivo de maíz en la Sierra del Ecuador (pp. 32). Instituto de Investigaciones Agropecuarias (INIAP).
Kim, P., Bai, H., Bai, D., Chae, H., Chung, S., Kim, Y., Park, R., & Chi, Y. T. (2004). Purification and characterization of a lipopeptide produced by Bacillus thuringiensis CMB26. Journal of Applied Microbiology, 97(5), 942-949.
Litsinger, J. A. (1989). Second generation insect pest problems on high yielding rices. Tropical Pest Management, 35(3), 235-242.
Liu, J., Hagberg, I., Novitsky, L., Hadj-Moussa, H., & Avis, T. J. (2014). Interaction of antimicrobial cyclic lipopeptides from Bacillus subtilis influences their effect on spore germination and membrane permeability in fungal plant pathogens. Fungal Biology, 118(11), 855-861.
Li, Y., Yang, S., & Mu, B. (2010). The surfactin and lichenysin isoforms produced by Bacillus licheniformis HSN 221. Analytical Letters, 43(6), 929-940.
Madslien, E., Rønning, H., Lindbäck, T., Hassel, B., Andersson, M., & Granum, P. (2013). Lichenysin is produced by most Bacillus licheniformis strains. Journal of Applied Microbiology, 115, 1068-1080.
Mahmood, I., Imadi, S. R., Shazadi, K., Gul, A., & Hakeem, K. R. (2016). Effects of pesticides on environment. In K. Hakeem, M. Akhtar, & S. Abdullah (Eds.), Plant, soil and microbes (pp. 253-269). Springer.
Mnif, I., Grau-Campistany, A., Coronel-León, J., Hammami, I., Triki, M. A., Manresa, A., & Ghribi, D. (2015). Purification and identification of Bacillus subtilis SPB1 lipopeptide biosurfactant exhibiting antifungal activity against Rhizoctonia bataticola and Rhizoctonia solani. Environmental Science and Pollution Research, 23(7), 6690-6699. https://doi.org/10.1007/s11356-015-5826-3
Mnif, I., Sahnoun, R., Ellouze-Chaabouni, S., & Ghribi, D. (2013). Evaluation of B. subtilis SPB1 biosurfactants’ potency for diesel-contaminated soil washing: Optimization of oil desorption using Taguchi design. Environmental Science and Pollution Research, 21(2), 851-861.
Morikawa, M., Hirata, Y., & Imanaka, T. (2000). A study on the structure-function relationship of lipopeptide biosurfactants. Biochimica Et Biophysica Acta (BBA) - Molecular and Cell Biology of Lipids, 1488(3), 211-218.
Mulligan, C., Cooper, D., & Neufeld, R. (1984). Selection of microbes producing biosurfactants in media without hydrocarbons. Journal of Fermentation Technology, 62(4), 311-314.
Ongena, M., & Jacques, P. (2008). Bacillus lipopeptides: Versatile weapons for plant disease biocontrol. Trends in Microbiology, 16(3), 115-125.
Ongena, M., Jacques, P., Touré, Y., Destain, J., Jabrane, A., & Thonart, P. (2005). Involvement of fengycin-type lipopeptides in the multifaceted biocontrol potential of Bacillus subtilis. Applied Microbiology and Biotechnology, 69(1), 29-38.
Ongena, M., Jourdan, E., Adam, A., Paquot, M., Brans, A., Joris, B., Arpigny, J. L., & Thonart, P. (2007). Surfactin and fengycin lipopeptides of Bacillus subtilis as elicitors of induced systemic resistance in plants. Environmental Microbiology, 9(4), 1084-1090.
OriginLab. (2018). OriginPro (Version 2018). OriginLab Corporation, Northampton, MA, USA.
Perez, K. J., Viana, J. D., Lopes, F. C., Pereira, J. Q., Santos, D. M., Oliveira, J. S., Velho, D. M., Crispim, S., Nicoli, J. R., Brandelli, A., & Nardi, R. M. (2017). Bacillus spp. Isolated from Puba as a Source of Biosurfactants and Antimicrobial Lipopeptides. Frontiers in Microbiology, 8, 61.
Peypoux, F., Bonmatin, J. M., & Wallach, J. (1999). Recent trends in the biochemistry of surfactin. Applied Microbiology and Biotechnology, 51(5), 553-563.
Płaza, G., Chojniak, J., Rudnicka, K., Paraszkiewicz, K., & Bernat, P. (2015). Detection of biosurfactants in Bacillus species: genes and products identification. Journal of Applied Microbiology, 119(4), 1023-1034.
Rajmohan, K. S., Chandrasekaran, R., & Varjani, S. (2020). A review on occurrence of pesticides in environment and current technologies for their remediation and management. Indian Journal of Microbiology, 60(2), 125-138.
Ramarathnam, R., Bo, S., Chen, Y., Fernando, W. D., Xuewen, G., & Kievit, T. D. (2007). Molecular and biochemical detection of fengycin- and bacillomycin D-producing Bacillus spp., antagonistic to fungal pathogens of canola and wheat. Canadian Journal of Microbiology, 53(7), 901-911.
Sambrook, J., & Russell, D. W. (2001). Molecular cloning: A laboratory manual. Cold Spring Harbor Laboratory.
Saranya, P., Bhavani, P., Swarnalatha, S., & Sekaran, G. (2015). Biosequestration of chromium (iii) in an aqueous solution using cationic and anionic biosurfactants produced from two different Bacillus sp. - a comparative study. RSC Advances, 5(98), 80596-80611.
Sherry, S. T., Ward, M. H., Kholodov, M., Baker, J., Phan, L., Smigielski, E. M., & Sirotkin, K. (2001). dbSNP: the NCBI database of genetic variation. Nucleic Acids Research, 29(1), 308-311.
Soberón-Chavez, G. (2011). Biosurfactants: From genes to applications. Springer.
St, L., & Wold, S. (1989). Analysis of variance (ANOVA). Chemometrics and Intelligent Laboratory Systems, 6(4), 259-272.
Thavasi, R., Jayalakshmi, S., Balasubramanian, T., & Banat, I. M. (2008). Production and characterization of a glycolipid biosurfactant from Bacillus megaterium using economically cheaper sources. World Journal of Microbiology and Biotechnology, 24(7), 917-925.
Wilson, C., & Tisdell, C. (2001). Why farmers continue to use pesticides despite environmental, health and sustainability costs. Ecological Economics, 39(3), 449-462.
Youssef, N. H., Duncan, K. E., Nagle, D. P., Savage, K. N., Knapp, R. M., & Mcinerney, M. J. (2004). Comparison of methods to detect biosurfactant production by diverse microorganisms. Journal of Microbiological Methods, 56(3), 339-347.
Zang, T., Wu, H., Yan, B., Zhang, Y., & Wei, C. (2021). Enhancement of PAHs biodegradation in biosurfactant/phenol system by increasing the bioavailability of PAHs. Chemosphere, 266, 128941.
